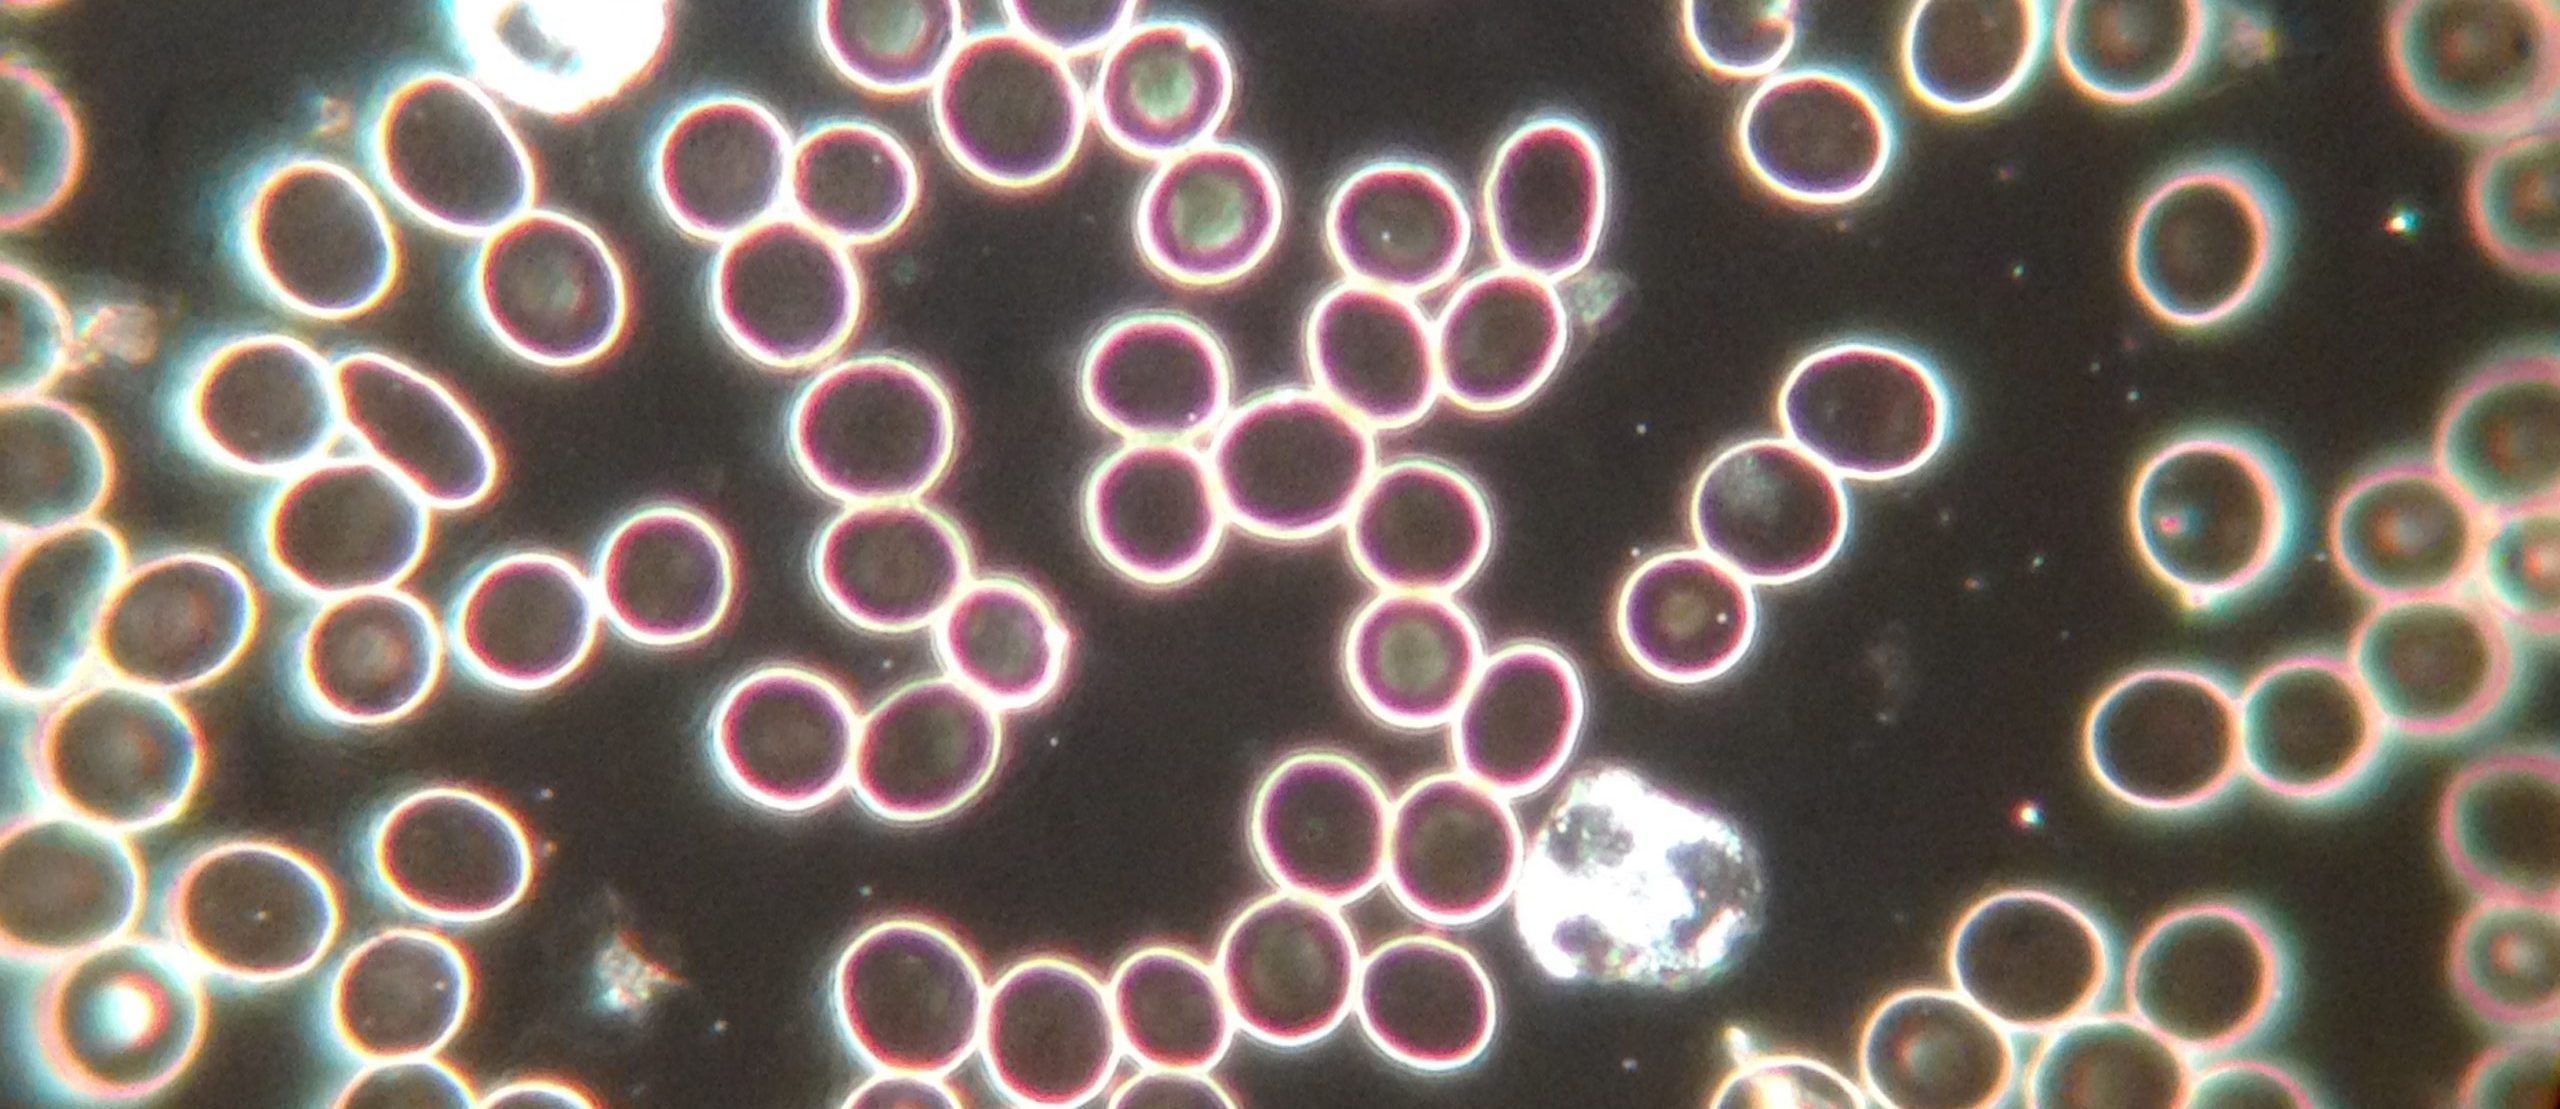

Dunkelfeldmikroskopie ist eine Mikroskopiermethode, die es ermöglicht, transparente Proben ohne Färbung zu beobachten. Sie basiert darauf, dass das Licht, welches die Probe durchstrahlt, nicht direkt in das Objektiv gelangt, sondern nur das von der Probe gestreute oder abgelenkte Licht betrachtet wird.
Diese Technik ist besonders wertvoll für die Beobachtung von lebenden, farblosen und transparenten Proben, wie z.B. Bakterien, Hefezellen, Plankton oder auch kleine Kristalle, da deren Strukturen im normalen Durchlichtmikroskop schwer zu unterscheiden wären.
Ein klares Plus der Dunkelfeldmikroskopie ist die Erzeugung eines hellen Bildes auf dunklem Grund – daher “Dunkelfeld”. Dieser Kontrast erleichtert oft die Erkennung von Strukturen und Bewegungen von Objekten, die sonst im Hellfeld (normalen Licht mit direkter Beleuchtung) nur schwer oder gar nicht sichtbar sind.
Dunkelfeldmikroskopie bleibt ein wichtiges Werkzeug in Biologie und Medizin und kann bei entsprechender Anwendung wertvolle Einblicke in Proben gewähren, die ohne Färbung oder andere invasive Präparationstechniken erhalten bleiben. Obwohl die Methode ihre Beschränkungen hat, ist sie eine ergänzende Methode, die in Kombination mit anderen mikroskopischen Techniken ein umfassenderes Verständnis biologischer und chemischer Prozesse auf kleinstem Niveau ermöglicht.